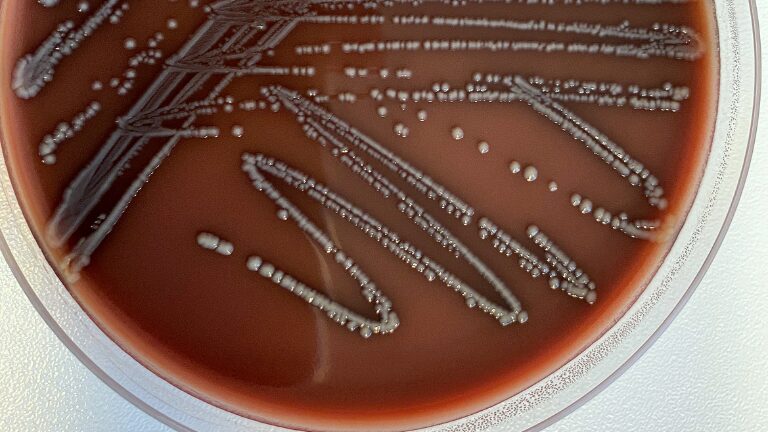

投稿日:2020年8月22日 最終更新日:2025年10月26日
こんにちは。蒲田、浜松町英会話教室パーキーです。
海外旅行に行くとよくストリートフードなど食べたりしますよね。
そこで運悪くなってしまうのが食中毒。
もし現地で病院を訪ねたりする時、自分の症状を説明できないと大変です。
今日はそんなときに使える例文と共に学んでいきましょう。
食中毒は英語で…?

食中毒は英語で、‘food poisoning‘ と言います。
foodは食べ物という意味ですよね。
poisoningが中毒や毒殺という意味があります。
このpoisoningは食べ物だけでなく薬物などの中毒にも使えます。
では少し前に食中毒にかかり、今もかかっている場合は何て言いましょうか?
例文を見てみましょう。
1.I’ve had food poisoning since last night.
昨晩から食中毒にかかりました。
では今は回復したけれど、その時に食中毒だった場合はどうでしょうか?
2.I got food poisoning when I was in India.
インドにいた時に食中毒になりました。
に、なります。
例文のように、食中毒には have と get が使えます。
have を使うと今まさに自分が食中毒の状態にあることを指します。
get はその時に食中毒状態でのちに回復した時に使います。
なので2の例文は
(今は回復したけれど、)インドにいた時に食中毒になりました。
と、動詞によって意味を暗示することができます。
ここに現在完了形のhaveを付け足すことで
自分はこの時に食中毒にかかって今もずっとその状態です。
と伝えることができます。
動詞と時制を上手く使う事で、今なっているのか、過去になっていたのか表せるんです。
なので医者に伝えたいときは1の例文のパターンを使うのが良いでしょう。
また、すっかり治ったことを伝えたい場合は、
I got food poisoning yesterday, but I feel good now!
昨日食中毒にかかったけど、今はもう大丈夫だよ!
と、getの通常の過去形を使えば大丈夫です。
food poisoningと間違えやすい単語
お腹の病気に関連する単語でもう一つ、胃腸炎って何というかご存知ですか?
それは、stomach fluです。
stomach は胃やお腹、flu はインフルエンザ(influenza) の短縮形の言い方です。
これはウイルス性のお腹の病気や胃腸炎を指します。
また、ただの腹痛であるstomachacheとはまた別物です。
この stomach flu も have と get で表せます。
I’ve had stomach flu for three days now.
もう3日も胃腸炎にかかっている。
I’ve got stomach flu today.
今日胃腸炎にかかりました。
ネイティブの方でもこの2つを同じ意味で使っている方がいるので混同しないように注意しましょう!
おわりに
いかがでしたでしょうか?
食中毒に関する使えるフレーズと共にご紹介しました。
当教室にはそんな素朴な疑問に答えてくれる優しいネイティブの先生がいらっしゃいます。
無料体験レッスンも行っておりますので興味のある方は是非下をクリック!
お待ちしております。

英語はじめてでも安心!英会話パーキーです。
